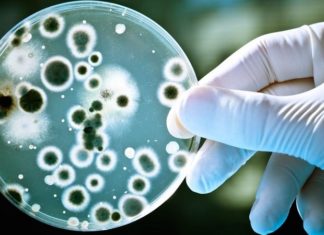
Is Boiled Water Good for You?

Tag: water contamination
Why You Should Never Pour Grease Down the Drain
It is estimated that just 1 liter of used cooking oil can contaminate up to 1 million liters of freshwater. This startling fact should encourage all of us to break this harmful habit and dispose of our used cooking oil responsibly.
Is Boiled Water Good for You?
Boiled water is a staple drink in our daily lives, but have you ever wondered if it's truly beneficial for your health? It's time to delve into the facts and uncover the truth about this seemingly mundane topic.